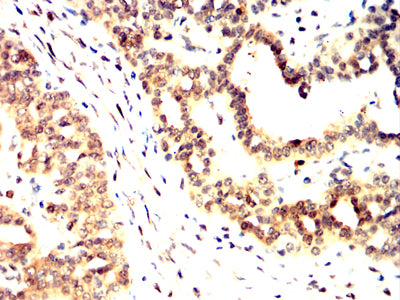

Mouse Monoclonal Antibody to PARK7
货号:
32363
别名:
DJ1; DJ-1; GATD2; HEL-S-67p
应用:
WB,IHC,FCM
反应种属:
Human
抗体类型:
Primary antibody
Swissprot:
Q99497
规格:
目录价
在线咨询
Description |
|---|
The product of this gene belongs to the peptidase C56 family of proteins. It acts as a positive regulator of androgen receptor-dependent transcription. It may also function as a redox-sensitive chaperone, as a sensor for oxidative stress, and it apparently protects neurons against oxidative stress and cell death. Defects in this gene are the cause of autosomal recessive early-onset Parkinson disease 7. Two transcript variants encoding the same protein have been identified for this gene. |
References |
|---|
| 1.Biochemistry (Mosc). 2021 Jun;86(6):627-640. 2.Sci Rep. 2021 Jul 16;11(1):14582. |
Specification |
|
|---|---|
| Aliases | DJ1; DJ-1; GATD2; HEL-S-67p |
| Entrez GeneID | 11315 |
| Swissprot | Q99497 |
| clone | 2B1D7 |
| WB Predicted band size | 19.8kDa |
| Host/Isotype | Mouse IgG1 |
| Antibody Type | Primary antibody |
| Storage | Store at 4°C short term. Aliquot and store at -20°C long term. Avoid freeze/thaw cycles. |
| Species Reactivity | Human |
| Immunogen | Purified recombinant fragment of human PARK7 (AA: 1-189) expressed in E. Coli. |
| Formulation | Purified antibody in PBS with 0.05% sodium azide |
Application |
|
|---|---|
| WB | 1/500 - 1/2000 |
| IHC | 1/200 - 1/1000 |
| FCM | 1/200 - 1/400 |
| ELISA | 1/10000 |
Product Image
-
Black line: Control Antigen (100 ng);Purple line: Antigen (10ng); Blue line: Antigen (50 ng); Red line:Antigen (100 ng)

-
Western blot analysis using PARK7 mouse mAb against A549 (1), A431 (2),K562 (3) and Hela (4) cell lysate.

-
Flow cytometric analysis of HepG2 cells using PARK7 mouse mAb (green) and negative control (red).

-
Immunohistochemical analysis of paraffin-embedded human cervical cancer tissues using PARK7 mouse mAb with DAB staining.

-
Immunohistochemical analysis of paraffin-embedded human ovarian cancer tissues using PARK7 mouse mAb with DAB staining.

鄂公网安备42018502007531号
鄂公网安备42018502007531号

